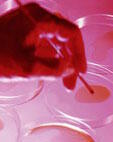

Stress oxydatif : mythes et réalités
| Créée en mars 2003, la Société française de médecine et de physiologie du vieillissement (SFMPV) est une jeune société savante dont l'ambition est de regrouper tous les professionnels de santé souhaitant réfléchir et se former en pathologie humaine appliquée au vieillissement, afin de pouvoir répondre au mieux aux attentes de leurs patients sur la qualité de leur vieillissement. Au cours sa 3e Journée nationale qu'elle a organisée le 18 juin dernier au groupe hospitalier Pitié-Salpêtrière sur le thème « Le stress oxydant : mythes et réalités », une partie du programme était consacré aux différentes méthodes actuelles de mesure du stress oxydant. Nous avons choisi de rendre compte d'un certain nombre de ces conférences. |
Évaluation du stress oxydant : Un mariage difficile avec la clinique1Dr Robert Nataf |
 |
 |
Depuis une quinzaine d'années que nous nous intéressons au stress oxydant, nous pouvons nous rendre compte qu'il a du mal à pénétrer la pratique clinique. Beaucoup de médecins, et la plupart des cardiologues, ne demandent pas le moindre test qui permettrait d'évaluer la contribution oxydative à la maladie cardio-vasculaire. Il existe plusieurs raisons à cela. D'une part, les techniques sont quelque peu délicates et exigent un matériel spécialisé. Ensuite, elles sont d'un coût élevé et ne sont pas prises en charge par la Sécurité sociale. D'autre part, le problème est que tout cela reste du domaine virtuel. |
|
Lorsque l'on parle de l'évaluation du stress oxydant, le praticien a du mal à rattacher les résultats qu'il obtient à une notion de maladie. Il manque au stress oxydant un étiquetage clinique des marqueurs : l'exploration de la composante oxydative d'une pathologie devrait faire appel à un marqueur qui lui serait lié, à défaut d'une spécificité, par rapport de causalité. |
|
Je vais d'abord évoquer le 8ohdG ou 8-hydroxy-désoxyguanosine. Ensuite, des marqueurs de la peroxydation lipidiques, c'est-à-dire des marqueurs de l'attaque oxydative des membranes : l'isoprostane et le MDA. Puis, je parlerai de l'allantoïne, un marqueur très peu connu du dommage oxydatif lié à l'exercice musculaire et à l'activité sportive. |
 |
Le 8ohdG urinaireLe génome de chacune de nos cellules subit à peu près 100 000 agressions chaque jour. Le principal agent des dommages du génome, c'est notre propre métabolisme. Nous produisons environ 5 g d'anion superoxyde par jour et sommes les principaux destructeurs de notre génome. |
|
 |
|
La 8ohdG, c'est, à l'intérieur de la chaîne de l'ADN, une attaque oxydative au niveau du carbone 8 de la guanine. Vous avez donc une oxydation de ce carbone 8 qui empêche soit la transcription soit la réplication. Intervient alors un système de réparation qui va exciser cette base endommagée qui sera relarguée dans le plasma et passera ensuite dans l'urine. |
| Qu'est-ce qui fait l'authenticité du 8ohdG ?
Nous savons que la longévité des espèces est liée à leur activité métabolique, c'est-à-dire à leur consommation d'oxygène. Le rat, par exemple, qui vit deux ou trois ans, produit plus de 1 000 picomoles de 8ohdG par kilogramme de poids. Le porc en produit à peu près 500 à 600 picomoles et vit une dizaine d'années. L'homme qui vit 80 ans produit 100 à 150 picomoles par kilogramme de poids. Nous avons entre les mains un marqueur spécifique de la longévité des espèces. À nous de montrer qu'il peut, s'il est affiné, devenir un marqueur spécifique de la longévité individuelle. |
|
Pourquoi ? Halliwell, qui est un grand spécialiste du stress antioxydant, a étudié la plaque athéromateuse. Il a pris, sur des artères de cadavres, des boues athéromateuses et y a mis des métaux, du fer et du cuivre. Il a constaté, le lendemain, que le fer était totalement rouillé et le cuivre totalement oxydé, notamment dans les plaques athéromateuses jeunes. Cela veut dire que la plaque athéromateuse est un bouillon oxydant, un milieu très prooxydant et que probablement le stress oxydant joue un rôle beaucoup plus important dans les maladies cardio-vasculaires ou dans les accidents cardio-vasculaires du sujet jeune. Les fumeurs ont un stress oxydant élevé et un taux de 8ohdG accru. |
 |
 |
On peut donc considérer le 8ohdG comme un marqueur du vieillissement. On peut également le considérer comme un marqueur de l'exposition toxique, notamment, les toxines qui créent justement des lésions sur le génome. On peut le considérer également comme un marqueur de la maladie cardio-vasculaire et il peut aussi servir de marqueur dans des essais de supplémentation en différents antioxydants. Cela permettrait d'affirmer que cette supplémentation pourrait avoir un pouvoir éventuel sur les dommages et, en cela, peut-être un effet sur la longévité. |
L'isoprostane F2 alphaNous avons tout à l'heure associé le dommage génétique au vieillissement. Parmi les pathologies concernées par les dommages oxydatifs, on trouve la plupart du temps les maladies cardio-vasculaires. |
|
Il est intéressant, dans les maladies cardio-vasculaires, de pouvoir mesurer la contribution oxydative. Classiquement, dans la maladie cardio-vasculaire, nous pensons athérome, maladies athéromateuses. La maladie athéromateuse, schématiquement, peut être assimilée à une maladie de membranes : membranes plaquettaires, membranes de l'endothélium vasculaire, membranes des LDL On peut considérer que les marqueurs de la peroxydation témoignant d'une attaque oxydative peuvent servir d'index de la contribution oxydative à la maladie athéromateuse et aux autres maladies cardio-vasculaires. Dans ce cas, nous dosons en laboratoire l'isoprostane F2 alpha. |
 |
| Qu'est-ce qui fait sa supériorité par rapport à tout ce que l'on peut doser en matière de peroxydation lipidique ?
D'abord, c'est un composé qui se forme in vivo et in situ. Les radicaux oxygénés viennent attaquer la molécule d'acide archidonique à l'intérieur de la cenapse membranaire. L'isoprostane F2 alpha est alors libérée de son phospholipide par une phospholipase. Après libération dans la circulation, l'isoprostane est excrétée dans les urines sous forme libre ou sous forme de métabolite. C'est donc un marqueur in situ. On ne peut pas penser que l'isoprostane F2 alpha puisse venir d'une autre structure que la membrane de la cellule des structures cellulaires d'enveloppe des LDL. |
|
Ensuite, l'isoprostane F2 alpha n'est pas un simple témoin. C'est un acteur de la maladie athéromateuse. On sait maintenant que l'isoprostane F2 alpha peut favoriser l'agrégation plaquettaire. Par ailleurs, elle possède un récepteur spécifique dans l'organisme, celui de la thromboxane A2, et peut agir sur ce récepteur en favorisant la multiplication des fibres lisses de la média. Or on sait que cette multiplication est une étape clé de l'athérogenèse. |
Le malonyl-dialdéhydeLe malonyl-dialdéhyde, nous le dosons depuis 15 ans. C'est un dosage que l'on fait en chromatographie. Il est en effet important d'avoir une technique séparative. Le réactif que l'on fait réagir dans le plasma pour mettre en évidence le malonyl-dialdéhyde peut aussi reconnaître d'autres molécules comme des prostaglandines, des sucres
qui peuvent donner des réactions. La chromatographie est une technique d'abord séparative qui permet de doser uniquement cette molécule très carbonée qu'est le malonyl-dialdéhyde. |
 |
L'allantoïneC'est un autre marqueur que nous sommes pratiquement les seuls à avoir développé en Europe. |
| Qu'est-ce que l'allantoïne ?
On recommande souvent, notamment en médecine du vieillissement, à des gens qui ont cessé d'en faire de reprendre une activité physique. La préoccupation est de se demander : « Est-ce que la reprise de l'exercice physique ne va pas majorer les dommages oxydatifs ? Est-ce que je ne vais pas induire un stress oxydant et accélérer le vieillissement ? » Nous savons que les sportifs professionnels de très haut niveau ont un stress oxydant accru et très souvent, pour certains, connaissent un vieillissement accéléré. |
|
Que se passe-t-il lorsque l'on fait un effort musculaire intense ? Le muscle peut consommer jusqu'à 200 fois plus d'oxygène que lorsqu'il est au repos. Lorsqu'il a consommé cet oxygène, même si les mitochondries sont plus grosses et mieux protégées, une explosion va se produire à l'intérieur de la cellule musculaire avec notamment des anions superoxyde et des ROS, les espèces oxygénées réactives. Le muscle, les infrastructures musculaires risquent d'être menacées par cette agression. À ce moment-là, le muscle va importer de l'acide urique. On le montre par des études très fines en faisant des prises de sang juste après l'effort musculaire et on observe que l'uricémie diminue. |
 |
 |
Cet acide urique qui est un puissant antioxydant va engager un combat contre ces espèces oxygénées. De ce combat va sortit l'allantoïne. En effet, l'acide urique piège efficacement le radical hydroxyle puis se transforme après réaction en allantoïne. Celle-ci va être relarguée dans le plasma, puis passe dans l'urine. Nous avons donc, à travers l'allantoïne, formée spécifiquement dans le secteur hydrophile de la cellule, encore plus exclusivement dans le muscle après l'effort, un marqueur du dommage oxydatif dans la cellule musculaire liée à l'effort de l'exercice physique. |
L'ADMA (asymmetric dimethylarginin)Ce que j'ai dit au niveau du stress oxydant est encore plus vrai au niveau du stress microradicalaire, c'est-à-dire au niveau du stress induit par les effets réactifs des dérivés de l'azote. En réalité ce n'est pas aussi simple parce que NO est un peu comme Janus. Il est bénéfique et il est néfaste. NO est bénéfique dans certains secteurs géographiques de l'organisme, dans certaines conditions. Il peut être délétère dans d'autres. |
 |
Produit en quantité équilibrée, sans excès de radicaux superoxydes, dans la paroi vasculaire, le NO diminue l'agrégation plaquettaire, l'adhésion à la paroi vasculaire des plaquettes et des éléments inflammatoires circulants à la paroi ainsi que la multiplication des fibrocytes de l'intima et il dilate les vaisseaux. Donc, dans ce cas, il exerce une action bénéfique. |
|
Lorsqu'elles sont dégradées, elles libèrent ce fameux ADMA. C'est un régulateur endogène de la NO synthase nécessaire à la production de l'acide nitrique. L'ADMA va inhiber cette NO synthase qui nous est profitable et permet de nous protéger de l'athérome. Plus le taux d'ADMA s'élève, plus la production de NO diminue. |
Dans la paroi vasculaire existe une enzyme, la DDAH, diméthylarginine diméthylaminohydrolase, qui détruit l'ADMA. Elle est très vulnérable face aux radicaux libres. La diminution des niveaux de la DDAH provoquée par le stress oxydant va permettre l'augmentation du niveau de l'ADMA, une inhibition accrue de la NO synthase et, par suite, une diminution de la production de NO au niveau vasculaire. Cela avec pour conséquences vasospasmes, hypertension et accélération du processus d'athérogenèse.

La première Superoxyde dismutase (SOD) à la biodisponibilté orale scientifiquement démontrée
test.supersmart.comTous droits de reproduction réservés
Gratuit
Merci de votre visite, avant de partir
inscrivez-vous auClub SuperSmart
d'avantages exclusifs:
- Gratuit : la publication hebdomadaire scientifique "Nutranews"
- Des promotions exclusives aux membres du club



 Format PDF
Format PDF













